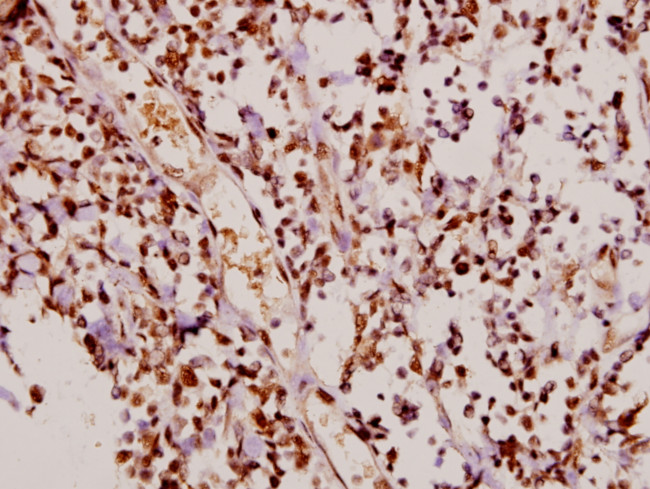
Phospho-p21 (Thr145) Antibody in Immunohistochemistry (Paraffin) (IHC (P))

Search
Invitrogen
Phospho-p21 (Thr145) Polyclonal Antibody
{{$productOrderCtrl.translations['antibody.pdp.commerceCard.promotion.promotions']}}
{{$productOrderCtrl.translations['antibody.pdp.commerceCard.promotion.viewpromo']}}
{{$productOrderCtrl.translations['antibody.pdp.commerceCard.promotion.promocode']}}: {{promo.promoCode}} {{promo.promoTitle}} {{promo.promoDescription}}. {{$productOrderCtrl.translations['antibody.pdp.commerceCard.promotion.learnmore']}}
产品信息
PA5-36677
宿主/亚型
分类
类型
抗原
偶联物
形式
浓度
保存条件
运输条件
RRID
产品详细信息
This antibody detects endogenous protein at a molecular weight of 21 kDa.
Purity is >95% by SDS-PAGE.
靶标信息
Protein p21 is a tumor suppressor protein which is an inhibitor of Cyclin-dependent kinases (CDK) and is transcriptionally activated by p53. P21 is important in the response of cells to genotoxic stress and a major transcriptional target of p53 protein. The occurrence of p21 in the nucleus executes binding and inhibition activity of cyclin dependent kinases Cdk1 and Cdk2, and blocks the transition from G1 phase into S phase or from G2 phase into mitosis after DNA damage, which enables the repair of damaged DNA. In the cytoplasm, p21 protein has an anti-apoptotic effect. P21 is able to bind to and inhibit caspase 3, as well as the apoptotic kinases ASK1 and JNK. P21 exhibits a dual function in carcinogenesis, and acts as a tumor suppressor, prevents apoptosis, and acts as an oncogene.
仅用于科研。不用于诊断过程。未经明确授权不得转售。